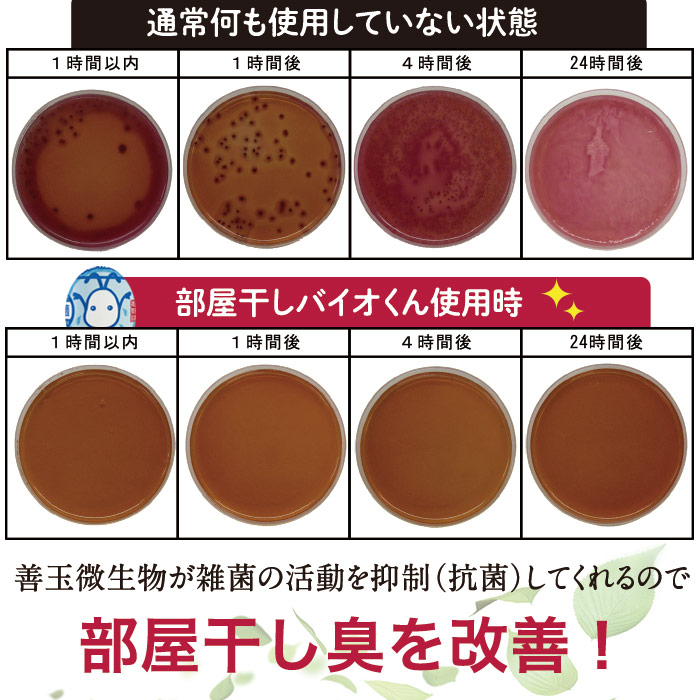

お客様のレビュー
ログインしてレビューを投稿する
【レビュー投稿についてのご注意】
・レビューは弊社にて確認後反映するため、1週間程度かかります。
・商品の感想から外れた内容の投稿は、非掲載となることがあります。
・内容に関し、投稿者に通知することなく、主旨が変わらない範囲で修正することがあります。
・レビューはカタログ紙面でご紹介させていただくこともございます。ご了承ください。
レビューを書き込む
*は入力必須項目です。
【レビュー投稿についてのご注意】
・レビューは弊社にて確認後反映するため、1週間程度かかります。
・商品の感想から外れた内容の投稿は、非掲載となることがあります。
・内容に関し、投稿者に通知することなく、主旨が変わらない範囲で修正することがあります。
・レビューはカタログ紙面でご紹介させていただくこともございます。ご了承ください。
まだレビューはありません